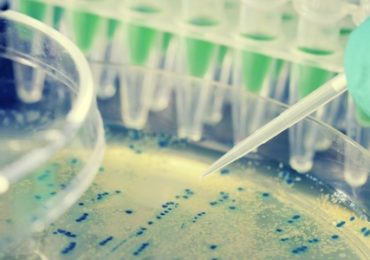

Des scientifiques ont étudié le rôle des bactéries ou microbiome local du tissu mammaire, sur le risque de développement du cancer du…
Search Results For: probiotiques
Des probiotiques pour réduire la toxicité du cadmium?
Des travaux chez la souris montrent que l’administration d’un probiotique permet de réduire l’assimilation intestinale…
Des probiotiques pour sauver l’os après la ménopause?
Des travaux menés chez la souris ovariectomisée montrent que des probiotiques peuvent sensiblement freiner la perte osseuse, en agissant notamment…
Les probiotiques ne font pas maigrir
Les probiotiques ne montrent pas d’effet significatif sur la perte de poids, selon une nouvelle méta-analyse, qui ne clôt pas pour autant le débat.…
Des probiotiques programmés pour lutter contre l’obésité?
Le traitement futur de l’obésité pourrait passer par des probiotiques programmés pour produire et délivrer, dans l’intestin, des molécules qui inhibent l’ap…
Pré- et probiotiques chez le nourrisson: importance du momentum
La recherche sur les probiotiques et les prébiotiques suggère un ensemble d’effets potentiels bénéfiques pour la digestion du nourrisson. Cependant, les eff…
Les refroidissements durent un peu moins longtemps avec les probiotiques
La consommation de probiotiques réduirait la durée moyenne des affections hivernales courantes d’environ 1 jour, selon une nouvelle méta-analyse publiée dan…
Probiotiques: et s’ils pouvaient privilégier la digestion des fibres?
En fonction des fibres consommées, certaines de nos bactéries intestinales peuvent ou ne peuvent pas digérer. Ces travaux menés à l’Université de York qui t…
Des probiotiques pour perdre du poids?
C’est ce que suggèrent des chercheurs de l’université de Laval, qui démontrent que le probiotique de la famille des Lactobacillus rhamnosus pourrait doubler…
Les probiotiques voient leur utilité reconnue dans certains domaines
Un panel d’experts traduit les connaissances actuelles sur les effets des probiotiques en indications cliniques qui peuvent être considérées comme consensue…